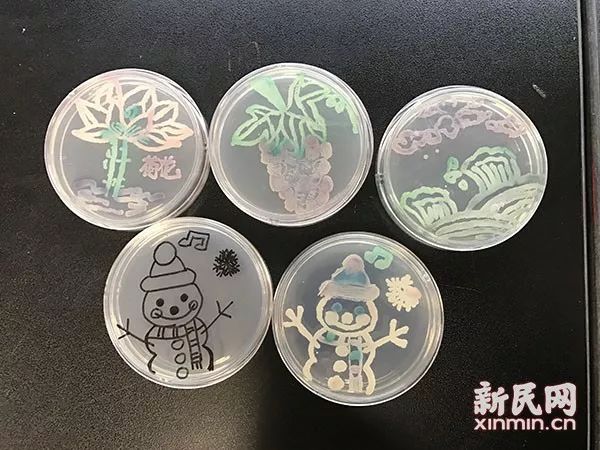

这些上海医生厉害了!在人体中“作恶”的霉菌竟能用来画画!
//www.workercn.cn 2017-12-27 07:28:57来源:新民晚报
| 分享到: | 更多 |

同仁医院检验科贾亦斐和孙晴的作品。受访者供图
相比日常做检验时的简单涂抹,用霉菌画画在尝试之初“技术难度”不小。比如蘸取的量就有讲究,蘸多了显色不利落,蘸少了显色不饱满。
“一开始的时候不太理想,有了经验第二次、第三次就基本能把握度了。”
编辑: 昕亚
| 编剧李樯创作《黄金时代》剧本 耗时三年半... | 2014-02-25 |
| 9卷本《杨绛全集》出版 《洗澡》续作单行... | 2014-02-25 |
| 《复旦英烈传》:讲述多位复旦校友抗战故事 | 2014-02-25 |
| 九位外国作家赴上海“驻市写作”2个月 | 2014-02-25 |
| 出版物未经许可收录网络文章 作者告上法庭... | 2014-02-25 |
| 《魅力情节》未经许可收录文章 作者讨说法 | 2014-02-25 |
| 朱大建作品集《静夜凝眸》出版 | 2014-02-25 |
| 1架上海飞马德里航班起飞不久后返航:乘客... | 2014-02-25 |
| 卧室房梁被白蚁蛀空!业主:头顶“悬梁”好... | 2014-02-25 |
| 年年都有一个“刘女士”死于泡脚?!泡脚真... | 2014-02-25 |
关于中工网 | 广告服务 | 版权声明 |
京公网安备 11010102002957号 | 中国互联网视听节目服务自律公约
互联网新闻信息服务许可证 (10120170038) | 信息网络传播视听节目许可证(0111630) | 京ICP备11015995号-1 | 联系我们:zgw@workercn.cn
广播电视节目制作经营许可证(广媒)字第185号 | 违法和不良信息举报 | 网络敲诈和有偿删帖举报电话:010-84151598
Copyright 2008-2022 by www.workercn.cn. all rights reserved
京公网安备 11010102002957号 | 中国互联网视听节目服务自律公约互联网新闻信息服务许可证 (10120170038) | 信息网络传播视听节目许可证(0111630) | 京ICP备11015995号-1 | 联系我们:zgw@workercn.cn
广播电视节目制作经营许可证(广媒)字第185号 | 违法和不良信息举报 | 网络敲诈和有偿删帖举报电话:010-84151598
Copyright 2008-2022 by www.workercn.cn. all rights reserved




